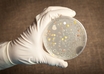

Removable balloon as good as permanent stent implant for arteries: The Lancet
ESC 2018 Press Release | Aug 29, 2018
Sri Ramachandra Institute sets up a Centre for Research
UNI | Aug 29, 2018
22 new AIIMS coming up across the country: Union Health Minister
PTI | Aug 28, 2018
AI system spots often-missed lung cancer tumours
IANS | Aug 28, 2018
New non-invasive test helps avoid unnecessary heart procedures: ESC 2018
ESC 2018 Press Release | Aug 28, 2018
Anthrax, a disease caused by a bacterium called Bacillus anthracis
UNI | Aug 28, 2018
Union Ministers lay foundation of satellite campus of AIIMS
PTI | Aug 27, 2018
Most read this week